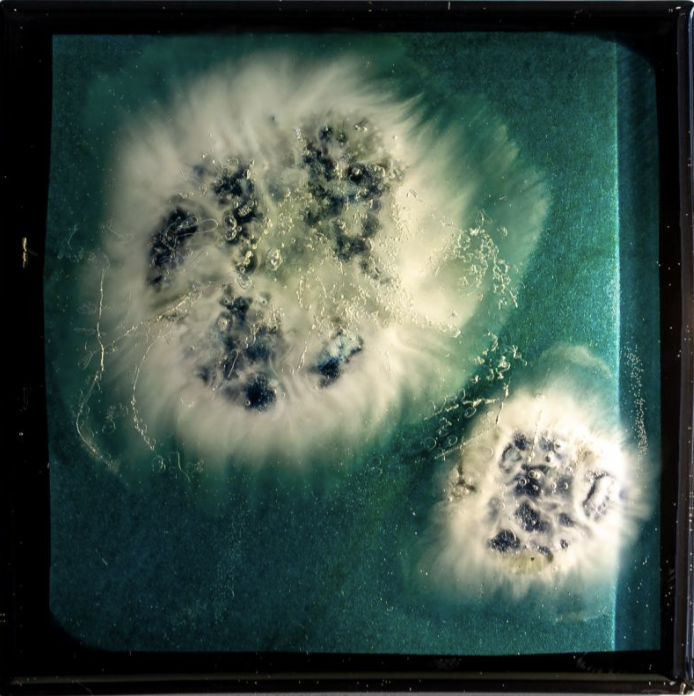
pH Value 20241006
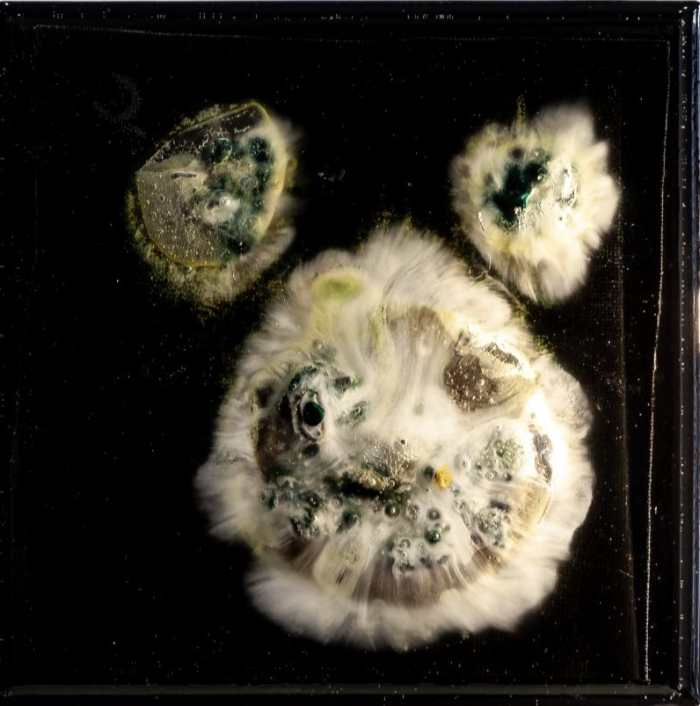
pH Value 20241011
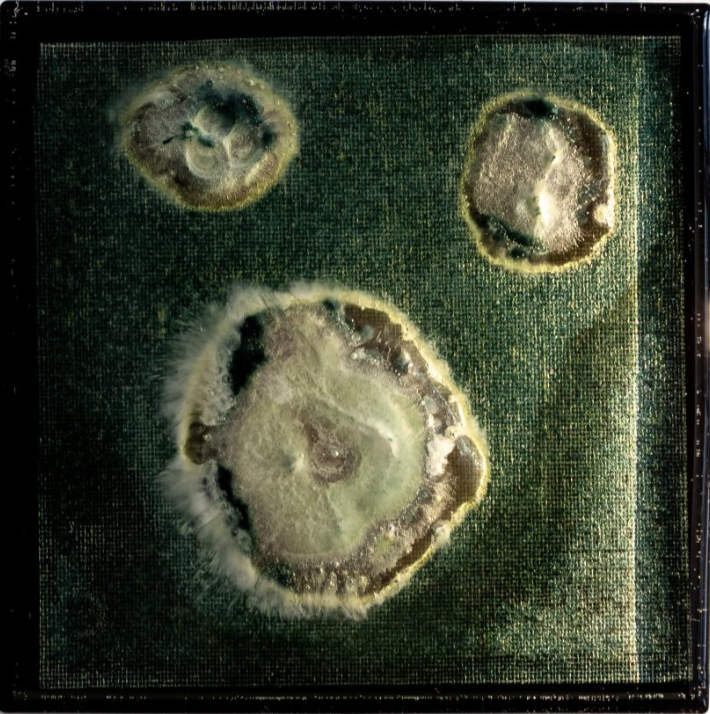
pH Value 20241013

Zhou Zhiyuan
More Works
红息20251023| Penicillium, Agar Medium, pH Test Strips, Epoxy Resin, Iron Plate| 46 × 33.8 × 4 cm| 2025
红息20251025| Penicillium, Agar Medium, pH Test Strips, Epoxy Resin, Iron Plate| 46 × 33.8 × 4 cm| 2025
红息20251026| Penicillium, Agar Medium, pH Test Strips, Epoxy Resin, Iron Plate| 46 × 33.8 × 4 cm| 2025
红息20251027| Penicillium, Agar Medium, pH Test Strips, Epoxy Resin, Iron Plate| 46 × 33.8 × 4 cm| 2025
红息20251029| Penicillium, Agar Medium, pH Test Strips, Epoxy Resin, Iron Plate| 46 × 33.8 × 4 cm| 2025
红息20251030| Penicillium, Agar Medium, pH Test Strips, Epoxy Resin, Iron Plate| 46 × 33.8 × 4 cm| 2025
红息20251105| Penicillium, Agar Medium, pH Test Strips, Epoxy Resin, Iron Plate| 46 × 33.8 × 4 cm| 2025
红息20251107| Penicillium, Agar Medium, pH Test Strips, Epoxy Resin, Iron Plate| 46 × 33.8 × 4 cm| 2025
红息20251109| Penicillium, Agar Medium, pH Test Strips, Epoxy Resin, Iron Plate| 46 × 33.8 × 4 cm| 2025
红息20251201| Penicillium, Agar Medium, pH Test Strips, Epoxy Resin, Iron Plate| 84.8 × 72.8 × 4 cm| 2025
pH Value 20250628| Penicillium, Agar Medium, pH Test Strips, Epoxy Resin, Iron Plate| 40 × 40 × 5 cm| 2025
pH Value 20250627| Penicillium, Agar Medium, pH Test Strips, Epoxy Resin, Iron Plate| 40 × 40 × 5 cm| 2025
pH Value 20250626| Penicillium, Agar Medium, pH Test Strips, Epoxy Resin, Iron Plate| 40 × 40 × 5 cm| 2025
Price Enquiry
For detailed pricing information, please contact us directly. Kindly include the work number when making your enquiry so we can assist you more efficiently.
We'll review your message and get back to you within 48 hours.